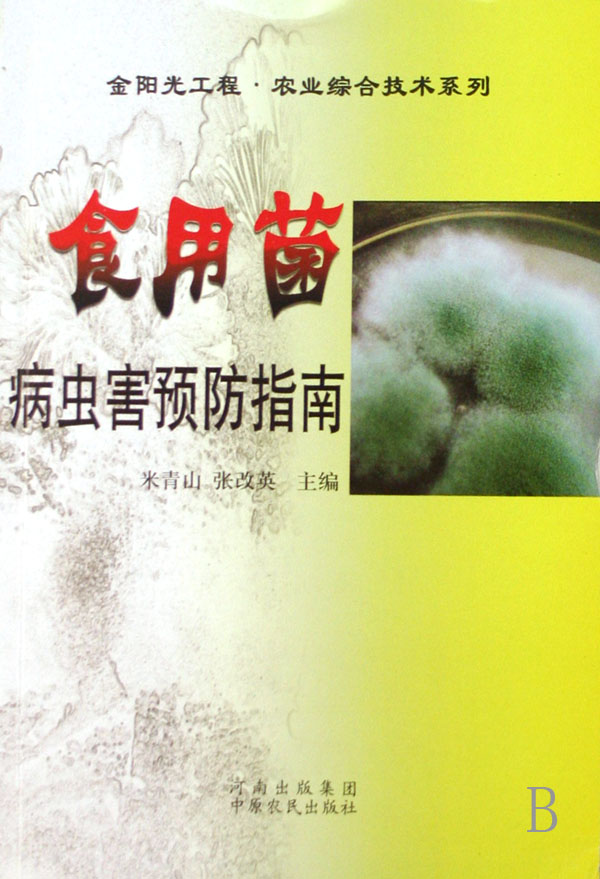

【丛编项】:无
【装帧项】:平装 32 / 196
【出版项】:中国农民出版社 / 2006-7
【ISBN号】:9787806419595 / 7806419594
【原书定价】:¥11.00
【图书简介】
Manbetx体育手机版推荐A9版本的重要价值已被人们所公认,其发展的速度十分惊人。据统计,我国食用据总产量1978年为6万吨,1990年突破100万吨,2000年为663万吨,2004年达1160万吨,已成为重要的出口创汇产品。Manbetx体育手机版推荐A9版本生产现已成为我国农业产业中的一项新兴产业,在全面建设小康社会、农村产业结构调整中,受到了各级领导的重视和广大农民群众的欢迎。本书共分四章。第一章介绍了Manbetx体育手机版推荐A9版本病虫害的基础知识;第二章介绍了Manbetx体育手机版推荐A9版本病虫害的危害症状及发生规律;第三章从预防的角度考虑,详细介绍了原料的选配、场地的建造、制种期、生产期,以及不同种类Manbetx体育手机版推荐A9版本病虫害的预防原则和措施;第四章针对可能发生的主要病虫害,从病原菌的形态、症状、发生特点及主要的预防措施等方面进行了阐述。编者根据长期的生产实践,总结和借鉴了前人和广大同行的宝贵经验,吸收国内外最新研究成果,编撰本书,以期对广大Manbetx体育手机版推荐A9版本生产者有一定的帮助和启发。








